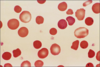

Block 1 Flashcards
Chromosomal mutation alpha thalassemia
Chromosome 16
Chromosome mutation beta thalassemia
Chromosome 11
Chronic myeloid leukemia mutation
t(9;22) - Philadelphia chromosome
Myelodysplastic disorder mutation
Deletion on chromosome 5 or 7
Myeloproliferative disorders mutation
JAK2 (tyrosine kinase)
B cell chronic lymphocytic leukemia has aberrant expression of ___
CD5 B cells have two digit markers T cells have single digit markers Plasma cells have triple digit markers
Follicular lymphoma mutation
t(14;18) Over expression of Bcl2 behind Ig promoter
Mantle cell lymphoma mutation
t(11;14)
Burkitt’s lymphoma mutation
t(8;14) c-MYC also t(8;22) or t(2;8)
Differentiate Hodgkin or non-Hodgkin lymphoma Age > 60 +/- B symptoms Single, generalized, non-contiguous lymphadenopathy B or T cell proliferation Variable prognosis
Non-Hodgkin
Differentiate Hodgkin or non-Hodgkin lymphoma Age variable Prominent B symptoms Contiguous, rarely generalized lymphadenopathy Reed-Sternburg, reactive cells Good prognosis
Hodgkin lymphoma
MC leukemia >60 yo Asymptomatic Lymphocytes, spleen, and LN Autoimmune hemolytic anemia Small, round lymphocytes, diffuse growth, proliferation centers. Smudge cells CD19+, CD20+, CD5+, CD23+ FMC7- Deletions or trisomies Indolent course
B cell lymphoma CLL or SLL
Generalized lymphadenopathy +/- B symptoms Follicular growth, mixed small and large cells Bone marrow paratrabaecular lymphoid aggregate CD19+, CD0+, CD10+ Germinal centers are Bcl2+ t(14;18) Bcl2 Indolent course
Follicular lymphoma
Chronic inflammation tissue mass Gastric (H. Pylori), thyroid (Hashimoto’s), eye, lung Epithelial destruction Gastric, diffuse infiltration by lymphocytes CD19+, CD20+ CD5-, CD10- t(11,18), resistant to antibiotics
Extranodal Marginal Zone Lymphoma (MALToma)
Splenomegaly, bone marrow fibrosis-dry tap, cytopenia Hairy cells Fried egg Myelofibrosis CD19+, CD20+, CD11c+, CD25+, CD103+ Tartrate resistant acid phosphatase (TRAP) BRAF mt Indolent course
Hairy cell leukemia
Waldenstrom Macroglobulinemia - IgM monoclonal protein - hyper-viscosity, vision, neuro, bleeding, cryoglobulin (Raynaud’s), lymphadenopathy, splenomegaly Lymphocytes and plasma cells Rouleux RBCs IgM serum protein CD19+ and CD20+ lymphocytes CD138+ plasma cells Indolent course
Lymphoplasmacytic lymphoma
Enlarging node/mass, B symptoms, de novo or transformation form low grade Common in HIV+, especially in brain Diffuse growth, large cells CD19+, CD20+, CD10 +/- Ki67 proliferation marker Aggressive course
Diffuse large B cell lymphoma
Enlarging node/mass (terminal ileum) B symptoms Endemic in jaw in Africa, 100% EBV Sporadic HIV+ Diffuse growth Starry sky (apoptosis) Basophilic cytoplasm vacuoles CD19-, CD20+, CD10+ Ki67+ proliferation marker t(8;14) c-MYC Aggressive course
Burkitt lymphoma
Lymphadenopathy, splenomegaly, GI tract, B symptoms Diffuse growth Cleaved cells CD19+, CD20+, CD5+, FMC7+ CD23- Cyclin D1 + t(11;14) cyclinD1 Promotes progression through the cell cycle Aggressive course
Mantle cell lymphoma
CRAB Calcium elevation Renal complications Anemia Bone disease Elderly, 2x blacks Increased infections Urine Bence-Jones protein Amyloidosis- Congo red stain, Apple green birefringence Lyric, punched-out lesions Hyper-viscosity- headaches, fatigue, bruising, GI bleeding, vision abnormalities just as retinopathy IgG >3g/dL (serum M spike) Plasma cells > 20-30% in bone marrow CD19-, CD20- CD138+ Cytoplasmic light chain Translocations, gains or deletions Progressive course
Plasma cell myeloma
Asymptomatic, labs negative IgG < 3g/dL Plasma cells < 10% 1% per year —> myeloma
Monoclonal gammopathy of unknown significance (MGUS)
Leukocytosis, lymphadenopathy, splenomegaly, hypercalcemia, rash HTLV1+ Japan, Caribbean, Africa -mycoses fungoides -Sezary syndrome Lymphocytosis Clover leaf, flower cell CD3+, CD4+ Reverse transcriptase + Aggressive
Adult T cell leukemia/lymphoma
Abdominal pain, weight loss, diarrhea, obstruction, celiac disease Small intestine, intraepithelial T cells Villous atrophy, ulcer, mass CD3+ Aggressive
Enteropathy associated T cell Lymphoma
Lymphadenopathy, extranodal sites Adult and children Large pleomorphic cells (hallmark cells) CD30+, ALK+, CD15- t(2;5) Good prognosis unless ALK-
Anaplastic large cell lymphoma
Destructive mass, commonly nasopharyngeal EBV associated Asia Destruction of blood vessels, necrosis CD3+, CD8+ T cells CD56+ NK cells Aggressive course
Extranodal NK/T cell lymphoma
Cutaneous lesions, patches, plaques, nodules Epidermotropism Pautrier’s microabscesses Cerebriform nuclei CD3+, CD4+ Indolent course Palliative treatment but not curative
Mycoses fungoides
Aggressive systemic variant of cutaneous T cell lymphoma Generalized erythroderma Lymphadenopathy Leukocytosis Cerebriform nuclei
Sezary syndrome
Unifocal- adults, lytic bone lesion Multifocal- children, multiple lytic lesions, skin, hepatosplenomegaly Oval cells, grooved cells Birbeck granules on electron microscopy CD1a+ S100+
Langerhans cell histiocytosis
Differentiate Classical Hodgkin’s (CHL) and Nodular Lymphocyte Predominant Hodgkin (NLPH) Age variable Single or contiguous LN Classical, lacunar, mononuclear cell type CD30+, CD15+ CD20- EBV+/- Good prognosis
CHL Includes: Nodular sclerosis Hodgkin lymphoma Mixed cellularity Hodgkin lymphoma Lymphocyte depleted Hodgkin lymphoma Lymphocyte rich Hodgkin lymphoma
Differentiate Classical Hodgkin’s (CHL) and Nodular Lymphocyte Predominant Hodgkin (NLPH) Male <35yo Single LN Nodular, RS cell Popcorn cells Background cells- lymphocytes CD20+ CD30-, CD15- EBV- Very good prognosis
NLPH
70% of all CHL Young patients Mediastinal +/- B symptoms Broad collagen bands Nodules Classic RS cell, lacunar cells Background cells: eosinophils, neutrophils, lymphocytes CD30+, CD15+ CD20- EBV+
Nodular sclerosis Hodgkin lymphoma
CHL Older patients B symptoms No fibrosis Classic RS cells Background cells: eosinophils, neutrophils, lymphocytes CD30+, CD15+ CD20- EBV ++
Mixed cellularity Hodgkin lymphoma
CHL Older adults HIV+ Developing countries No fibrosis Classic RS cells Background cells: histiocytes and fibroblasts CD30+, CD15+ CD20- EBV+
Lymphocyte depleted Hodgkin lymphoma
CHL rare Young patients usually no B symptoms Nodular growth Classic RS cells Background cells: lymphocytes CD30+, CD15+ CD20- EBV+ infrequent
Lymphocyte rich Hodgkin lymphoma
Splenectomy increases risk of infection with ___ bacteria
Encapsulated
Epithelial neoplasm of the thymus Lymphocytes are non neoplastic Adults with SOB and a mediastinal mass Paraneoplastic syndrome Myasthenia gravis Pure red cell aplasia Graves, pernicious anemia, dermatomyositis Tx: resection Invasion decreases outcome
Thymoma
Identify the disease

Iron deficiency anemia
Hypochromic and microcytic RBCs
Identify the disease

Anemia of chronic disease
Increased Ferritin
Decreased serum iron
Decreased transferrin
Decreased % saturation
Decreased TIBC
Increased FEP
Identify the disease

Sideroblastic anemia
Identify the diseases (2)

Target cells
EITHER:
sickle cell anemia (normocytic, extravascular hemolysis)
B thalassemia (microcytic)
Identify the diseases (2)

Expanded hematopoiesis
EITHER:
sickle cell anemia (normocytic, extravascular hemolysis)
B thalassemia (microcytic)
Identify the diseases (2)

Megaloblastic anemia
Either: B12 or folate deficiency
Enlarged RBCs and WBCs, including neutrophils which appear as hypersegmented
Identify the cell type
Appears in ___ anemias

Reticulocytes
Normocytic anemias
Identify the disease
Hereditary spherocytosis
Extravascular hemolysis and normocytic anemia
Identify the disease

Sickle cell anemia
Extravascular hemolysis and normocytic anemia
Identify the disease

Hemoglobin C
HbC crystals in RBCs
Extravascular hemolysis and normocytic anemia
Identify the substance present in this slide

Hemosiderin
Iron storage not readily available
Identify the disease

G6PD
Heinz bodies and Bite cells
Identify the disease

Immuno hemolytic anemia (IHA)
RBC agglutination, can be due to IgG or IgM
Identify the disease

Microangiopathic hemolytic anemia
Schistocytes and Helmet cells
Identify the disease

Aplastic anemia
Bone marrow is replaced by fat cells
Normocytic anemia with decreased production of RBCs
Differentiating leukemoid reaction from CML
Leukemoid reaction:
Asymptomatic or symptomatic?
Present/not toxic granulation?
Present/not basophils?
Present/not increased alkaline phosphatase?
Present/not altered genetics?
Symptomatic
Present toxic granulation
Absent basophils
High LAP
Normal genetics
Identify the disease

Leukemoid Reaction
Band cells
high LAP
ABSENT BASOPHILS (CML)
Identify the disease

CML
PRESENT BASOPHILS
Increased blast cells (left shift)
Low LAP
t(9;22)
Infectious Mono or B cell lymphoma (CLL/SLL)?
young patient
Fever, pharyngitis, LN and splenomegaly
Acute
Atypical lymphocytes
Positive Monospot/EBV
Normal flow cytometry
Self-limiting
Infectious mononucleosis
Identify the disease

Infectious mononucleosis
Atypical but BENIGN lymphocytes
Identify the disease

B cell lymphoma (CLL/SLL)
small lymphocytes with condensed chromatin and scant cytoplasm
Smudge cells
Identify the disease
2:1 kappa:lambda light chain ratio

Reactive follicular hyperplasia
Normal light chain ratio, therefore not malignant (malignant shows 1 LC)
Identify the disease

Polycythemia vera
Giant platelets
Hypochromia as a result of repeated phlebotomy
PV or Secondary Polycythemia?
Elevated WBC and platelets
Splenomegaly
Normal o2
low EPO
Bone marrow shows all myeloid cells
Abnormal genetics, JAK2 mt
Polycythemia Vera
Identify the disease

Essential thrombocytosis
Elevated platelets
Increased megakaryocytes
Identify the disease

Primary Myelofibrosis
Leukoerythroblastic reaction
Tear-drop RBC
Nucleated RBC
Myeloid precursors
(Bone marrow shows fibrosis)
Identify the disease

Myelodysplastic Syndrome
Peripheral smear shows dysplastic/bilobed neutrophils (Pseudo-Pelger-Huet cells)
Bone marrow is hypercellular with megakaryocytes
Ringed sideroblasts also present
Identify the disease

AML - acute myeloid leukemia
Myeloblasts with Auer rods, azurophilic granular material
Identify the disease
CD34+
TdT+

Acute lymphoid leukemia (ALL)
Identify disease

Follicular lymphoma
Equally sized abnormal follicles
Identify the disease

MALToma
Invades gastric mucosa
Identify the disease

Hairy cell leukemia
Identify the disease

Lymphaplasmacytic lymphoma
Identify the disease
Bcl2+

Follicular lymphoma
(Follicular hyperplasia shows unevenly sized follicles and Bcl2-)
Identify the disease

Diffuse large b cell lymphoma (DLBCL)
Identify the disease

Burkitt lymphoma
Starry sky (apoptosis)
Basophilic cytoplasmic vacuoles
Identify the disease

Mantle cell lymphoma
Cleaved cells
Identify the disease

Burkitt’s lymphoma
Starry sky (apoptosis)
Identify the disease
Lytic, punched out lesions of __ cel myeloma

Plasma cell myeloma
Identify the disease

Rouleaux cells of Plasma cell Myeloma
Identify the disease

Clover leaf cells of
Adult T cell lymphoma/leukemia (ATLL)
Identify the disease
Large pleomorphic cells of ___?

Anaplastic large cell lymphoma
Identify the disease

Mycoses Fungoides
Pautrier’s microabscesses
Epidermotropism
Cerebriform nuclei
___ cells are usually present in ___ Hodgkin Lymphoma

Reed-Sternberg cells in Classical Hodgkin’s lymphomas
Identify cell type and disease

Grooved nuclei of Langerhans cell Histiocytosis
Identify structure and disease

Birbeck granules of Langerhand cell Histiocytosis
___ Hemostasis
Platelet adhesion and activation by binding to exposed subendothelial ECM. Secreted products recruit other platelets to form a temporary hemostatic plug.
Primary
____ Hemostasis
Activation of the coagulation cascade by the release of tissue factor. Polymerized fibrin and platelet aggregates together form a solid, permanent plug.
Secondary
Activation of counter-regulatory mechanisms by ___ restricts the hemostatic plug to the site of injury to break down the clot.
tissue plasminogen activator (tPA)
Platelet (GpIb) to ECM (exposed collagen) adhesion is mediated by _____?
vWF
Aggregation is reversible and caused by the release of ___ from already adhered platelets.
ADP
Platelet-to-platelet adhesion is mediated by what platelet protein and what other molecule?
GpIIb/IIIa
Fibrinogen
Defect in GpIIb/IIIA is called ?
Glanzman Thrombasthenia
Deficiency of GpIb is called ?
Bernard-Soulier syndrome
Deficiency of platelet adhesion to exposed collagen is called ?
vWF disease
The fibrinolytic system is mediated mainly by ___ which acts primarily on fibrin to cleave clots. Also activates complement system by cleaving C3 into C3a and C3b.
Broad-spectrum endopeptidase
fibrin –> TPA and FSPs
Elevated breakdown products in thrombotic states such as DIC
Plasmin
Alpha-2 antiplasmin and alpha-2 macroglobulin are ____ inhibitors, which prevent the cleavage of clots (decreased fibrinolysis).
plasmin
___ is an inhibitor of clotting factors II, IX, X, and XII, thrombin, proteins C and S, plasmin, and kallikrein
Potentiated by heparin
Antithrombin-III
___ inhibits Vit-K dependent clotting factors II, VII, IX, and X
Coumadin (Warfarin)
(2)
Vit K dependent protease inhibitors
First activated by thrombin-thrombomodulin complex and inhibits factors V and VIII in the presence of its cofactor (2)
Proteins C and S
Defects in ___ hemostasis typically present as petechiae, whereas defects in ____ hemostasis present as bleeding into joints and soft tissue.
Primary
Secondary
Disease?
An autoimmune disorder associated with IgG or other processes
Platelet phagocytosis by splenic macrophages, but normal sized spleen
Prolonged bleeding
Normal PT, PTT
Increased megakaryocytes in bone marrow
Tx: glucocorticoids in chronic disease
Immune Thrombocytopenic Purpura (ITP)
Disease?
Formation of abnormal Ab that activate platelets after treatment with clot inhibitor
Leads to thrombocytopenia and arterial thrombosis (life threatening)
Heparin-induced Thrombocytopenia (HIT)
Disease?
Impaired platelet production and increased destruction lead to thrombocytopenia
CD4 and CXCR4 on megakaryocytes allow these cells to be infected. Then they are prone to apoptosis and their ability to produce platelets is impaired.
HIV Associated Thrombocytopenia
Disease?
Excessive activation of platelets, which deposit as thrombi in small vessels
Can cause microangiopathic hemolytic anemia and widespread organ dysfunction.
Consumption of platelets leads to thrombocytopenia
Deficiency in platelet enzyme ADAMTS13 (vWF metalloprotease), normally degrades vWF
Neuro symptoms
Thrombotic Thrombocytopenic Purpura (TTP)
ITP or TTP?
Ig attack platelets
Acute and Chronic
No thrombosis
Hemorrhage
Large immature platelets
Steroids or splenectomy

ITP - Immune thrombocytopenic purpura
ITP or TTP?
Microangiopathic hemolytic anemia
Schistocytes (helmet cells)
Thrombosis
Hemorrhage
Neuro symptoms
ADAMTS13 deficiency

TTP - thrombotic thrombocytopenic purpura
Disease?
Childhood onset
Verotoxin-producing E. coli O157:H7
Absorbed in gastric mucosa where it alters endothelial cell function and results in platelet activation and aggregation
Bloody diarrhea
Petechiae
Increased renal failure
Hemolytic Uremic Syndrome (HUS)
___ irreversibly inhibits COX and can suppress the synthesis of TXA2, necessary for platelet aggregation.
Aspirin
Disease?
MC inherited bleeding disorder
spontaneous bleeding from mucous membranes, menorrhagia
plasma levels measured as Ristocetin cofactor activity, which is reduced
Increased bleeding time
Normal platelet count
von Willebrand Disease
Disease?
Factor VIII deficiency
X-linked recessive; inversion of X abolishes synthesis of Factor VIII
MC hereditary disease associated with life-threatening bleeding
massive, spontaneous hemorrhage
Prolonged PTT
Normal PT
Hemophilia A
Disease?
Factor IX deficiency
X-linked recessive
Hemophilia B
Christmas Disease
Disease?
acute or chronic activation of the coagulation cascade
consumption of coagulation factors
Widespread microthrombi and microangiopathic hemolytic anemia
Thrombi in all organs
2 major mechanisms trigger this disease: release of tissue factor or other procoagulants into circulation OR widespread endothelial injury
Schistiocytes and helmet cells
Disease secondary to malignancy, obstetrics, sepsis, trauma, uncontrolled bleeding, surgery, etc.
Decreased platelet count and fibrinogen
Increased bleeding time, PT, and PTT
Increased fibrin split products and D dimer
DIC - Disseminated intravascular coagulation
Disease?
post-transfusion fever and chills within 6 hours
Attributed to release of donor leukocyte inflammatory mediators
Responds to antipyretics
Increased incidence with increased blood storage time
Febrile nonhemolytic reaction
Spontaneous abortion is most commonly caused by what?
Chromosomal abnormalities (MC trisomies)
Others include: infection, endocrine abnormality, uterine abnormality, immunologic dysfunction, or teratogenic causes
___ abortion
Uterine bleeding without cervical dilation, 50% will abort
Tx: bed rest
Threatened
____ abortion
Uterine bleeding with cervical dilation
100% will abort
Tx: curettage
Inevitable
___ abortion
Some products of conception remain in the uterus
Tx: curettage
Incomplete
___ abortion
Intrauterine fetal death without onset of labor
tc: curettage
Missed
____ abortion
3+ consecutive spontaneous abortions
Habitual
____ abortion
infection of products of conception along with infection of upper genital tract
Tx: antibiotic and evacuation
Septic
Pregnancy outside the uterine cavity, most commonly the fallopian tube ampulla.
Risk: PID, previous incidence, adhesions, endometriosis, previous surgery, IUD, in vitro fertilization
Classic triad: unilateral pelvic or lower abdominal pain, vaginal bleeding, tender adnexal mass following 2-6 weeks of amenorrhea
Abrupt onset of excruciating abdominal pain with rapid progression to shock, indicative of tubal rupture.
Dx: serum bHCG, ultrasound, laparoscopy/biopsy. Presence of chorionic villi is essential
ectopic pregnancy
What trimester is this placenta currently in?

First trimester
Chorionic villi composed of a delicate mesh of central stroma surrounded by two discrete layers of epithelium
outer = syncytiotrophoblast
inner = cytotrophoblast
What trimester is this placenta currently in?

Third trimester
Chorionic villi composed of stroma with a dense network of dilated capillaries surrounded by markedly thinned-out syncytiotrophoblast and cytotrophoblast layers, which appear as one layer.
Disease?
Low lying placenta, especially one that covers the cervical os.
Severe hemorrhage can result in cervical dilation and early delivery
Painless vaginal bleeding without any warning after 28 weeks
Complete, partial, or marginal
Intrauterine fetal growth retardation
Can also be complicated by placenta accreta
Placenta previa
Disease?
Lack of formation of the decidual plate, thus, chorionic villi extend into myometirum. The placenta cannot separate normally following delivery.
Results in severe hemorrhage
Placenta accreta
Disease?
Premature separation of the placenta prior to delivery with the formation of a retroplacental blood clot. Blood supply, therefore oxygen and nutrients, to the fetus is compromised.
Risk: HTN, prior incident, maternal age, multiparty, cocaine, cigarettes, trauma
Painful vaginal bleeding, uterine tenderness, fetal distress, shock, DIC
After 30 weeks (third trimester)
Abruptio placenta
Disease?
Umbilical cord inserted into the sides of the membrane, rather than the central part of the placental tissue

Velamentous placenta
Disease?
Separate placental lobes

Succenturiate lobes
Disease?
Expansion of maternal surface centrally unto the fetal surface

Circumvellate placenta
___ placenta

Bipartite (almost two)
MCC postpartum hemorrhage
Uterine atony
Disease?
In monochorionic twins, the donor twin sometimes becomes anemic and the recipient becomes plethoric
Twin-twin transfusion syndrome
Disease?
Infection of fetal membranes, amnion and chorion
Usually ascending infection from the genital tract
E. coli, group B strep, and gonorrhea
Premature rupture of membrane and early delivery

Acute chorioamnionitis
Disease?
A dense band-like inflammatory exudate on the amniotic surface
Acute inflammatory cells

Acute chorioamnionitis
Disease?
Acute inflammation of the placental cord

Acute funisitis
Disease?
Infection of chorionic villi

Villitis (placentitis)
Disease?
HTN, edema and proteinuria in pregnancy
Usually nulliparous
Severe disease can cause headaches, dizziness, and visual disturbances
HELLP: hemolytic anemia, elevated liver enzymes, low platelets
Pre-eclampsia
Disease?
HTN, edema, and proteinuria in pregnancy that progress to seizures and DIC
Eclampsia
Tx for grand mal seizure control
(used in eclampsia)
MgSO4
Disease?

Placental infarct
Disease?
Maternal vascular lesion observed in pre-eclampsia and idiopathic intrauterine growth retardation
Characterized by fibrinoid necrosis of the vessel wall, an accumulation of lipid-laden macrophages, and a mononuclear perivascular infiltrate

Acute atherosis
Disease?
No fetal parts or normal chorionic villi
Entire uterus is filled with edematous, avascular villi with the appearance of a bunch of grapes. Trophoblastic proliferation of both syncytio- and cytotrophoblasts with atypia.
46XX or 46XY
Empty ovum fertilized by either (more commonly) one sperm (with subsequent chromosome duplication) or two sperm without duplication
Increased bHCG
Ultrasound: snowstorm pattern
Increases risk of choriocarcinoma

Complete hydatidiform mole
Disease?
Villous enlargement, edema, and trophoblastic proliferation of both syncytio- and cytotrophoblasts with atypia.

Complete hydatidiform mole
Disease?
Only part of the placenta shows changes.
Fetal parts along with normal placental structures in the unaffected portion
69 XXY triploidy
one or two sperm fertilize a NORMAL egg
does not usually increase the risk of choriocarcinoma

Partial hydatidiform mole
Disease?
Only part of the placenta shows changes.
Fetal parts along with normal placental structures in the unaffected portion
69 XXY triploidy
one or two sperm fertilize a NORMAL egg
does not usually increase the risk of choriocarcinoma

Partial hydatidiform mole
Disease?
Malignant cytotrophoblasts and syncytiotrophoblasts
Uterine bleeding
Elevated bHCG
Widespread metastases are common
Risk: molar pregnancy, spontaneous abortion, 25% normal pregnancy

Choriocarcinoma
Disease?
Malignant cytotrophoblasts and syncytiotrophoblasts
Uterine bleeding
Elevated bHCG
Widespread metastases are common
Risk: molar pregnancy, spontaneous abortion, 25% normal pregnancy

Choriocarcinoma